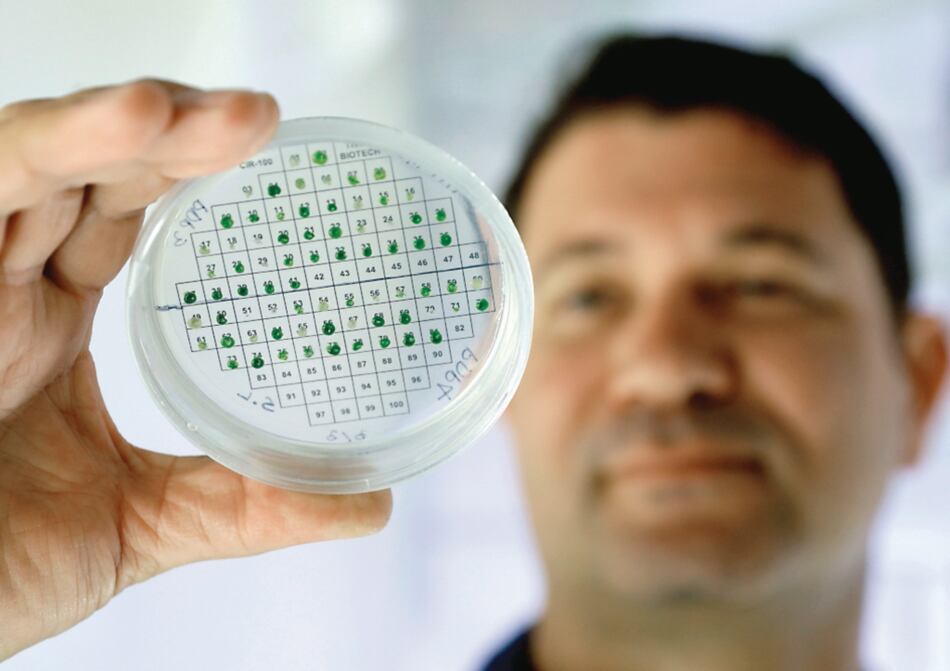
Investigadores en Israel producen electricidad a partir de plantas

Científicos de la universidad de Tel Aviv consiguieron, tras años de investigación, producir electricidad a partir de plantas, lo que demuestra que éstas pueden ser una fuente de energía limpia.
Este estudio fue publicado por la revista científica británica Energy and Environmental Science, y estuvo dirigido por el profesor Iftach Yacoby, director del laboratorio de energías renovables de la facultad de Ciencias de la Vida de la Universidad de Tel Aviv, en colaboración con el profesor Kevin Redding, de la universidad de Arizona, Estados Unidos.
El estudio demuestra que las plantas tienen capacidad de producción eléctrica particularmente eficaz, basada en el proceso de la fotosíntesis.
Según Yacoby, todas las plantas verdes, hojas, hierba o algas contienen verdaderos “paneles solares”, y pueden transformar un rayo de luz en una corriente de electrones. El desafío es extraer esta corriente de las plantas, según el profesor.
“Para hacer funcionar un aparato eléctrico, simplemente conéctelo a una toma de corriente. En el caso de una planta, (aún) no sabemos dónde enchufarlo. Hemos buscado un nanoenchufe trabajando con microalgas”, a las cuales hemos inyectado una enzima que produce hidrógeno con la ayuda de un bioreactor, explica.
Las microalgas desarrollaron células que contenían la nueva enzima y los investigadores concluyeron en que producían electricidad.
El profesor Yacoby afirmó estar convencido de que será “una nueva era para la agricultura que, después de haber alimentado a los humanos durante milenios, podrá utilizarse para producir energía”.
El estudio lleva casi seis años de trabajo.